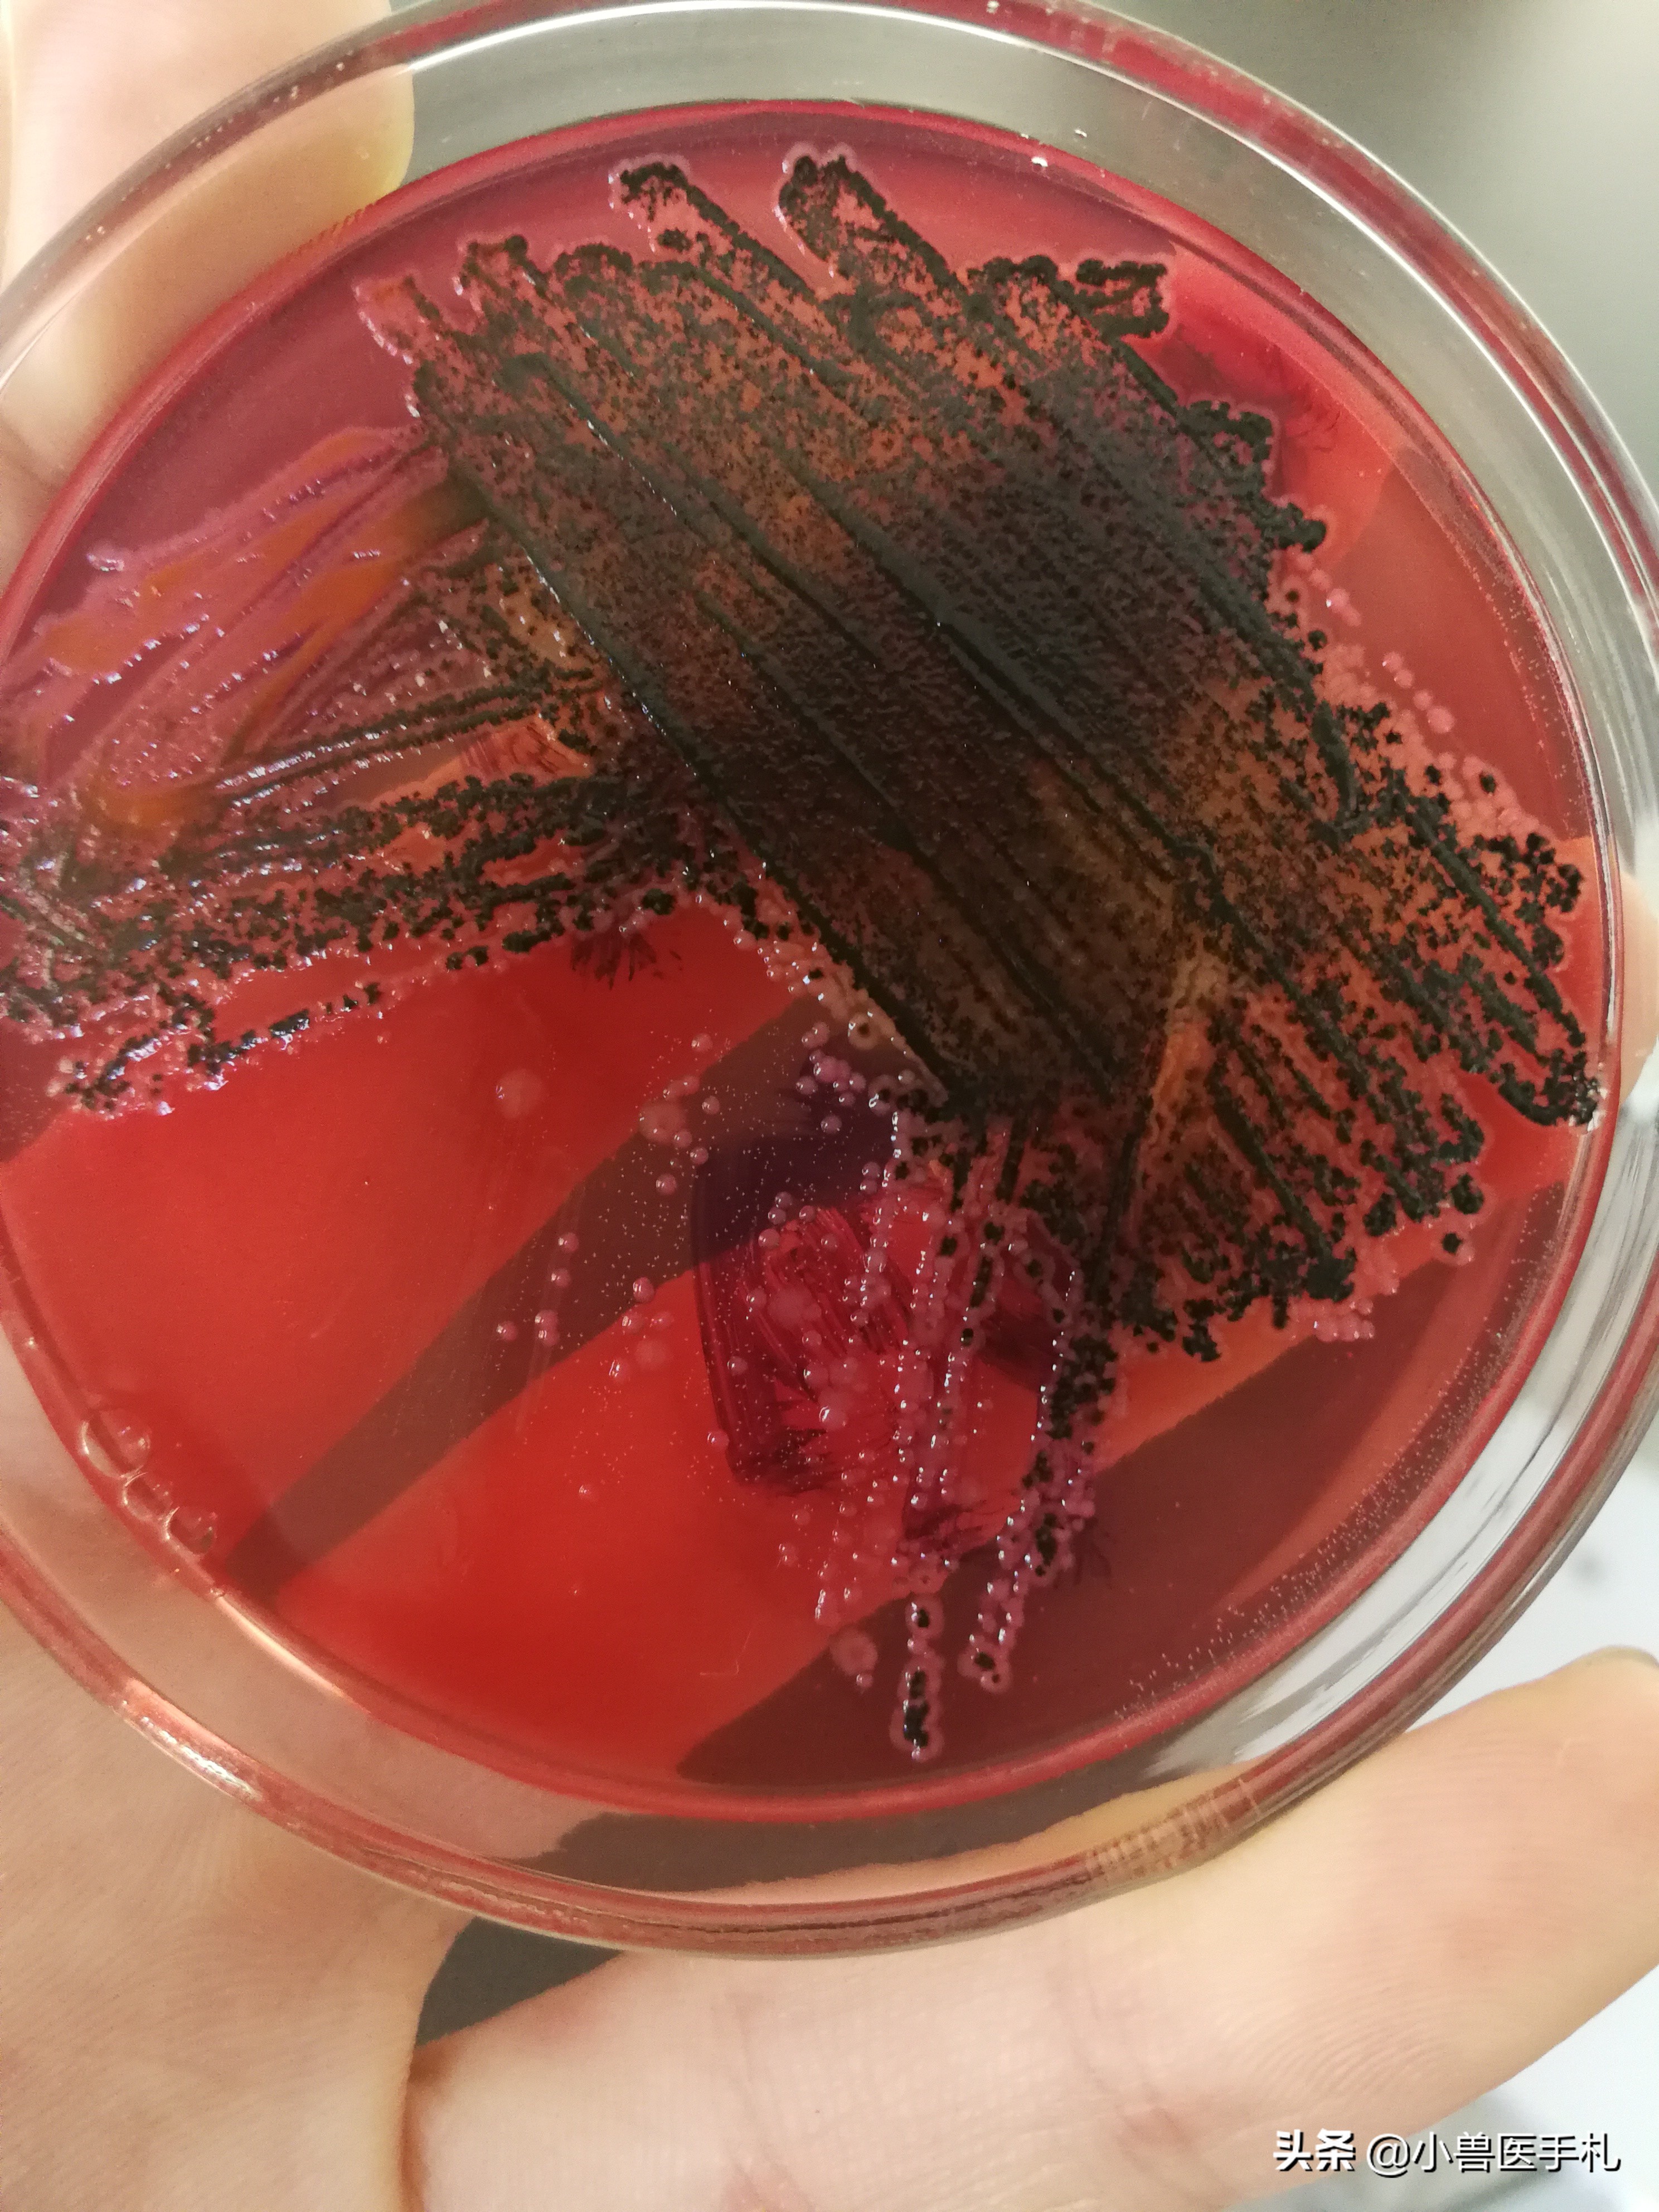
猪：副猪、链球菌、沙门、PCV、MHP病例分享

4.1号病例分享(猪)
今天小兽医给大家分享一个大猪场的病例,希望对广大养猪户朋友有所帮助。本文章较长,望耐心看完。如果您有什么想法可以在面留言,我们一同讨论,一起学习,一同进步。
2019.04.01。黑龙江某猪场有部分仔猪死亡,该厂自建厂以来,保育阶段的猪就有反复发病的症状,季节性极强,一般为断奶七天后出现呼吸道症状,咳喘,患病猪被毛粗乱,发病率大约在10%左右。该猪场对仔猪进行过伪狂犬,圆环,猪瘟进行过免疫。
一:取该厂死亡仔猪进行剖检:
1)死亡仔猪被毛粗乱,消瘦,眼睑有分泌物,皮肤苍白。
2)下颌淋巴结出血,肿胀,切面呈大理石样。喉头水肿。
3)腹股沟淋巴结微肿胀,皮下水肿。
4)腹腔内有大量纤维素渗出,淡黄色积液。出现珍珠状肋骨。
5)肠系膜水肿,回盲口正常。
6)脾脏出血,肝脏肿大,表面附着大量纤维蛋白。
7)胸腔黏连,有纤维素渗出。肺脏硬化,肉样变,间质性肺炎。

下颌淋巴结肿大

腹腔纤维素渗出

腹腔积液

肝脏上附着纤维素

间质性肺炎

肺坏死,硬化

肾脏坏死

肠道充血
二:对死亡仔猪进行细菌检测与病毒检测:
1)细菌检测
a)取肺部组织样进行血平板培养基需氧培养,TSA培养基二氧化碳培养。肠内溶物用SS鉴别培养基培养。
b)血平板培养基出现典型的肺炎链球菌,TSA培养基出现副猪嗜血杆菌,SS培养基出现沙门氏菌。
SS鉴别培养基上的沙门氏菌

血平板培养基上的链球菌(针尖状)
2)药物敏感度检测
细菌名称 敏感药物
a)沙门氏菌 链霉素 庆大霉素 阿米卡星 泰拉霉素 新霉素
b)链球菌 恩诺沙星 阿米卡星 新霉素
c)副猪嗜血杆菌 多粘菌素B 恩诺沙星 新霉素 强力霉素 头孢噻呋钠 庆大霉素 氟苯尼考
3)病毒检测
本次检测对CSFV 、 PRRSV 、 PRV 、 PCV、 MHP进行检测。
4)病毒检测结果
PCV、 MHP结果为阳性,其余为阴性。
PS:1)仔猪出现珍珠状肋骨为缺钙,补钙即可。
2)CSFV(猪瘟)、PRRSV(蓝耳)、PRV(伪狂犬)、PCV(圆环)、MHP(气喘病)。